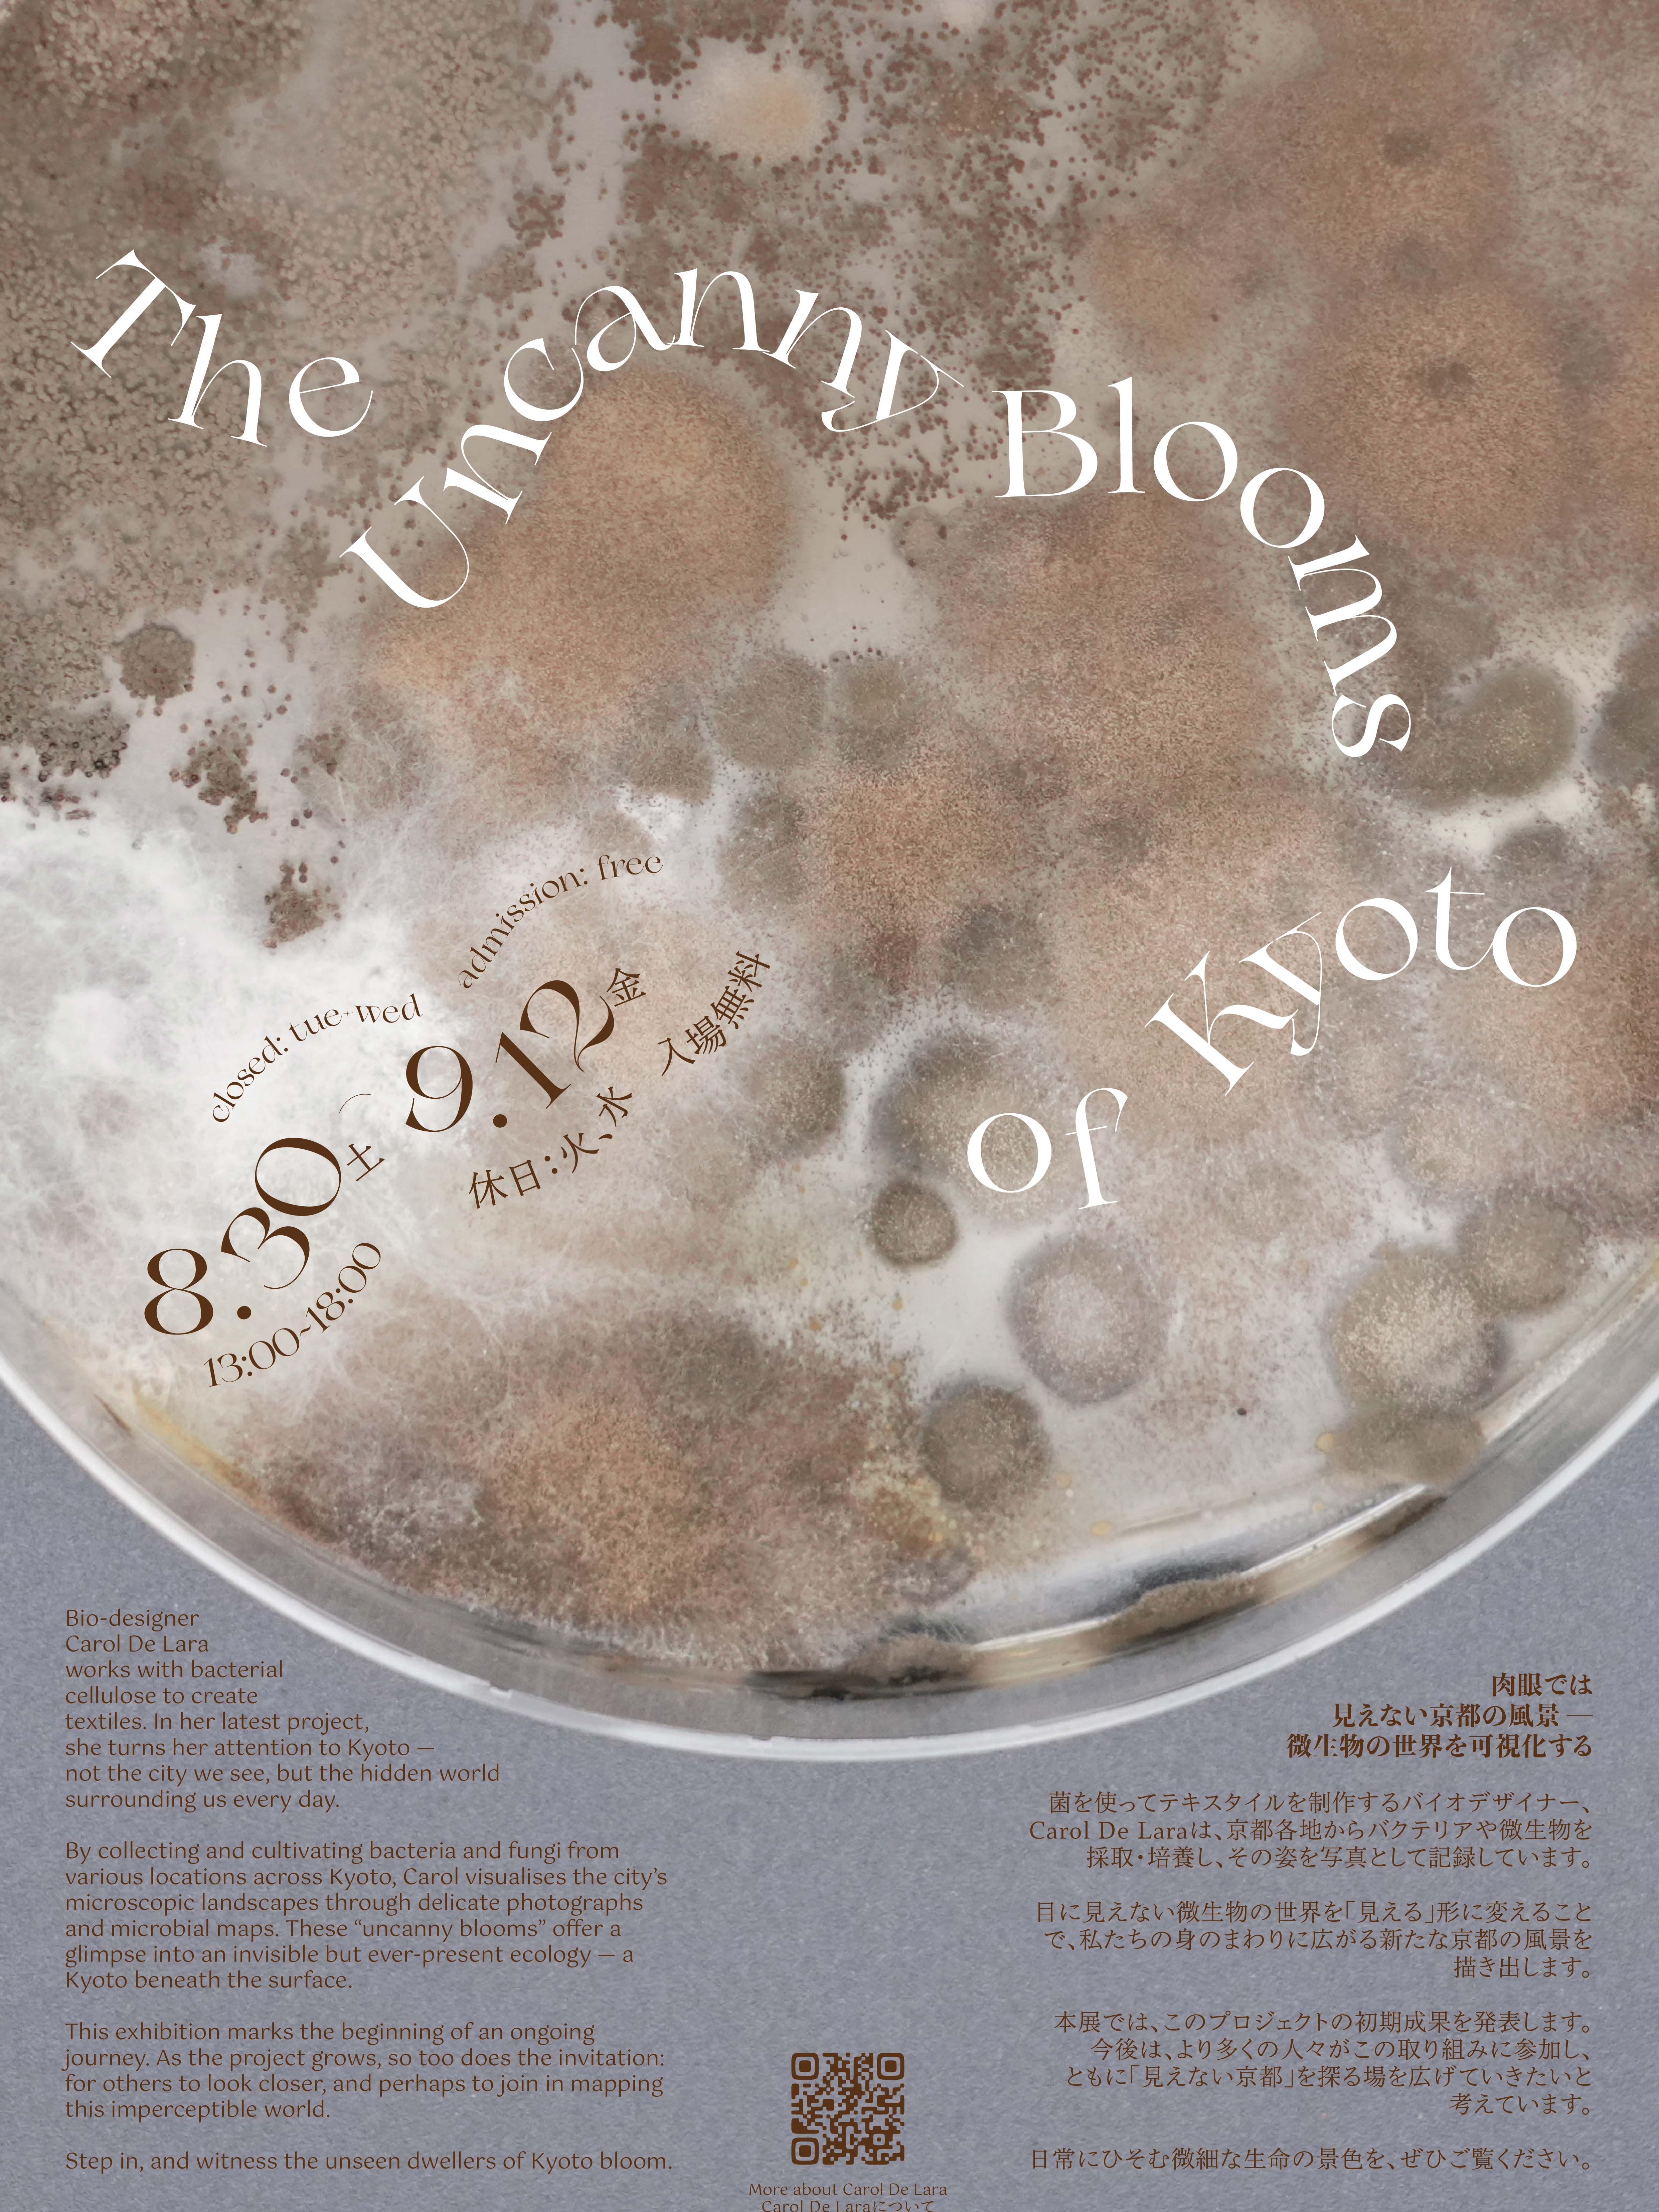

The Uncanny Blooms of Kyoto

Bacterial Brickbats

Mobilis in Mobili

The Alchemy of SCOBY

SHOEXPERSON.PNG

Kintsugi「菌次ぎ」

The Little Library of SCOBY

La Petit Morte

No Longer Human

Organic Fallacy

BA_002